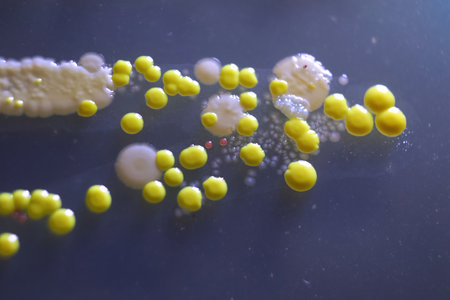
Macro view of bacteria and baker yeast colonies.の写真素材

写真素材 - Macro view of bacteria and baker yeast colonies.
キーワード
- agar
- aureus
- bacteria
- bacterium
- biochemistry
- biology
- biotechnology
- blue
- cerevisiae
- closeup
- cocci
- colonial
- colonies
- colony
- common
- culture
- dish
- experiment
- fungi
- germs
- growth
- identify
- infection
- laboratory
- macro
- media
- medical
- medium
- micro
- microbial
- microbiology
- microbiota
- microorganisms
- organism
- petri
- plate
- research
- saccharomyces
- safety
- science
- scientific
- spheres
- staphylococcus
- streak
- yeast
- yellow
類似作品
Laboratory petr...
close-up of bac...
Colony of blue ...
Examining bacte...
close-up of bac...
Penicillium, as...
This close up c...
Microscopic bac...
Mold Beautiful,...
A microbiologis...
bacteria colony...
Close up of col...
Diverse colorfu...
Fresh donut ser...
Threads of fung...
Surface contami...
Dental milling ...
Science and Lif...
Close-up of ger...
Backgrounds of ...
A close up of c...
Macro close up ...
Digital art, il...
close-up of sci...
Close-up detail...
Bacteria on a w...
Colorful bacter...
Surface with ba...
Colorful micros...
microbial cultu...
Backgrounds of ...
Close-up of bac...
Close up view r...
Scientist holdi...
Close up detail...
bacteria colony...
Scientific imag...
Parasite eggs, ...
Close up cup of...
Dynamic motion ...
Mold Beautiful,...